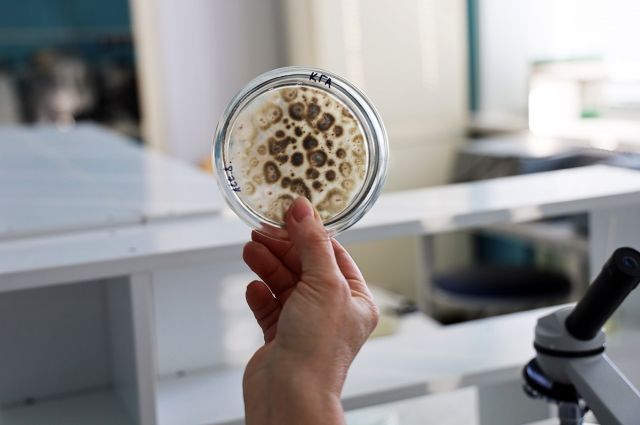
AGTU, kuraklığa dayanıklı mikroorganizmalı biyogübre geliştirdi

Astrahan Devlet Teknik Üniversitesi (AGTU) bilim insanları, kuraklık ve tuzluluğa dayanıklı yerel mikroorganizmalar içeren yeni bir biyogübre geliştirmek için hibe desteği aldı. Ürünün domates başta olmak üzere birçok tarım bitkisinde verimi artırabileceği belirtiliyor.
Rusya’nın Astrahan Bölgesi’nde faaliyet gösteren Astrahan Devlet Teknik Üniversitesi’nin (AGTU) “Uygulamalı Biyoloji ve Mikrobiyoloji” Bölümü, tarımsal verimliliği artırmaya yönelik yeni bir biyogübre geliştirme çalışmaları için hibe desteği aldı.
Proje, Yenilikleri Destekleme Fonu tarafından yürütülen “UMNIK” programı kapsamında desteklenen biyoteknoloji girişimleri arasında yer aldı. Geliştirilen biyolojik preparatın temelinde, bitkiler için biyolojik olarak aktif maddeler üreten faydalı mikroorganizmalar bulunuyor.
Üniversite tarafından yapılan açıklamaya göre bu mikroorganizmalar, bitki büyümesini hızlandırmanın yanı sıra bitkilerin bağışıklık sistemini harekete geçirerek çevresel stres koşullarına karşı dayanıklılığı artırıyor.
Biyogübrenin testleri, Astrahan Bölgesi’nde yaygın olarak yetiştirilen tarım ürünleri üzerinde gerçekleştirildi. Özellikle farklı erkenci ve orta erkenci domates çeşitlerinde olumlu sonuçlar elde edildi. Araştırmalar, preparatın tohum çimlenmesini artırabildiğini, fide gelişimini yüzde 180’e kadar hızlandırdığını ve gövde gelişimini yüzde 100 oranında teşvik ettiğini ortaya koydu.
Bilim insanları, ürünün yalnızca domatesle sınırlı kalmayacağını; sebzeler, kavun-karpuz grubu ürünler, tahıllar ve baklagillerde de kullanılabileceğini belirtiyor.
Preparatta kullanılan bakterilerin, bölgedeki bitkilerin kök çevresi toprağından elde edilmesi, biyogübrenin kuraklık ve tuzluluk gibi zorlu iklim koşullarına karşı yüksek uyum göstermesini sağlıyor. Bu özellik, özellikle güney iklim kuşağında daha çevreci ve düşük maliyetli tarım uygulamalarına katkı sunabilecek bir gelişme olarak değerlendiriliyor.
Araştırmacılar, yerel mikroorganizma suşlarının benzer iklime sahip bölgelerde daha yüksek etki göstereceğini, farklı toprak yapılarında ise ek saha denemelerine ihtiyaç duyulacağını vurguluyor.
Kaynak:Tarım Pusulası






















































Yorum Yazın